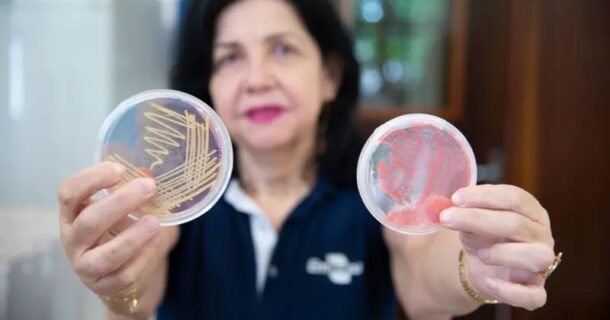
nobel de engenharia

Brasileira vence Nobel da Agricultura com fertilizantes biológicos
A ciência brasileira tem muito o que comemorar! Recentemente, uma engenheira do nosso país, chamada Mariangela Hungria da Cunha, microbiologista [...]

Conheça a Colheitadeira Gigante que Vai Revolucionar o Agronegócio Brasileiro
A Agrishow é a maior feira de inovação agrícola da América Latina. A edição 2025, realizada em Ribeirão Preto, São [...]

Descubra como a Seneca Dairy está transformando fazendas leiteiras com inovação
A inovação sempre foi o motor que impulsiona o aprimoramento dos processos produtivos e a competitividade dos negócios. No setor [...]

Robôs inteligentes e o futuro da engenharia com o 3DEXPERIENCE Lab e a AgreenCulture
Nos últimos anos, a agricultura moderna tem enfrentado um grande dilema: altos investimentos em maquinário e baixos retornos financeiros. Em [...]

Conheça o LaserWeeder, um robô com IA e laser para combater ervas daninhas na agricultura
Atualmente, todos os setores da engenharia enfrentam desafios quanto à escassez de mão de obra e necessidade urgente de práticas [...]

Fazendas sem agricultores? Você vai se surpreender com os planos de Elon Musk para o agro brasileiro
Já conversamos algumas vezes aqui, no Engenharia 360, sobre o comportamento de Elon Musk. O empresário é conhecido mundialmente por [...]

Veja imagens do veleiro usado pelo Brasil para levar café e cacau à Europa com menos poluição
O Brasil é um dos maiores exportadores de café e cacau do mundo. Mas além de se preocupar com a [...]

Produtor na Coreia do Sul usa laser autônomo para reduzir perdas na lavoura de soja
A agricultura enfrenta vários desafios complexos. Já reparou nas pequenas plantações, que os donos colocam aqueles espantalhos? Isso é para [...]

Curte vinho? Vinícola italiana faz uso de painéis solares para melhorar sua produção
A Itália é conhecida por sua arte, cultura, comida e bebida, é claro. Terra dos mais lindos vinhedos, também é [...]

Pesquisa comprova benefícios do biocarvão na produção de hortaliças
Biocarvão é um material carbonizado resíduo fino gerado durante a fabricação de carvão vegetal a partir da pirólise de biomassa. [...]
